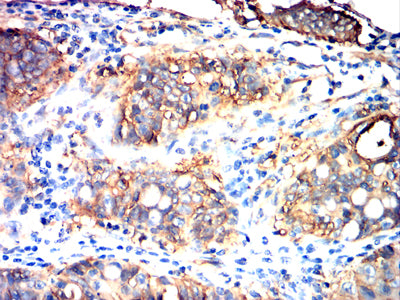

Mouse Monoclonal Antibody to TSPAN8
货号:
32178
别名:
CO-029; TM4SF3
应用:
WB,IHC,FCM
反应种属:
Human
抗体类型:
Primary antibody
Swissprot:
P19075
规格:
目录价
在线咨询
Description |
|---|
The protein encoded by this gene is a member of the transmembrane 4 superfamily, also known as the tetraspanin family. Most of these members are cell-surface proteins that are characterized by the presence of four hydrophobic domains. The proteins mediate signal transduction events that play a role in the regulation of cell development, activation, growth and motility. This encoded protein is a cell surface glycoprotein that is known to complex with integrins. This gene is expressed in different carcinomas. The use of alternate polyadenylation sites has been found for this gene. |
References |
|---|
| 1,Int J Oncol. 2018 Feb;52(2):473-484. 2,Biomolecules. 2020 Mar 3;10(3):388. |
Specification |
|
|---|---|
| Aliases | CO-029; TM4SF3 |
| Entrez GeneID | 7103 |
| Swissprot | P19075 |
| clone | 8A4A10 |
| WB Predicted band size | 26 kDa |
| Host/Isotype | Mouse IgG1 |
| Antibody Type | Primary antibody |
| Storage | Store at 4°C short term. Aliquot and store at -20°C long term. Avoid freeze/thaw cycles. |
| Species Reactivity | Human |
| Immunogen | Purified recombinant fragment of human TSPAN8 (AA: Extra(110-205)) expressed in E. Coli. |
| Formulation | Purified antibody in PBS with 0.05% sodium azide |
Application |
|
|---|---|
| WB | 1/500 - 1/2000 |
| IHC | 1/200 - 1/1000 |
| FCM | 1/200 - 1/400 |
| ELISA | 1/10000 |
Product Image
-
Black line: Control Antigen (100 ng);Purple line: Antigen (10ng); Blue line: Antigen (50 ng); Red line:Antigen (100 ng)

-
Western blot analysis using TSPAN8 mouse mAb against HT-29 cell lysate.

-
Flow cytometric analysis of HepG2 cells using TSPAN8 mouse mAb (green) and negative control (red).

-
Immunohistochemical analysis of paraffin-embedded human liver cancer tissues using TSPAN8 mouse mAb with DAB staining.

-
Immunohistochemical analysis of paraffin-embedded human rectal cancer tissues using TSPAN8 mouse mAb with DAB staining.

-
Immunohistochemical analysis of paraffin-embedded human stomach cancer tissues using TSPAN8 mouse mAb with DAB staining.

鄂公网安备42018502007531号

